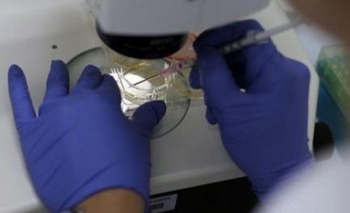
Imagen de la nota: La provincia investiga como regenerar órganos con células madre

Política
Raúl Pitarque: "la llegada del virus Zika es para estar atentos"
El Dr. Raúl Pitarque, quien se desempeña como Director de Redes y Regiones Sanitarias de la Provincia de Buenos Aires habló sobre la preocupante propagación de los virus del Dengue y Zika en el país más la situación del sistema de Salud provincial.
Comunidad